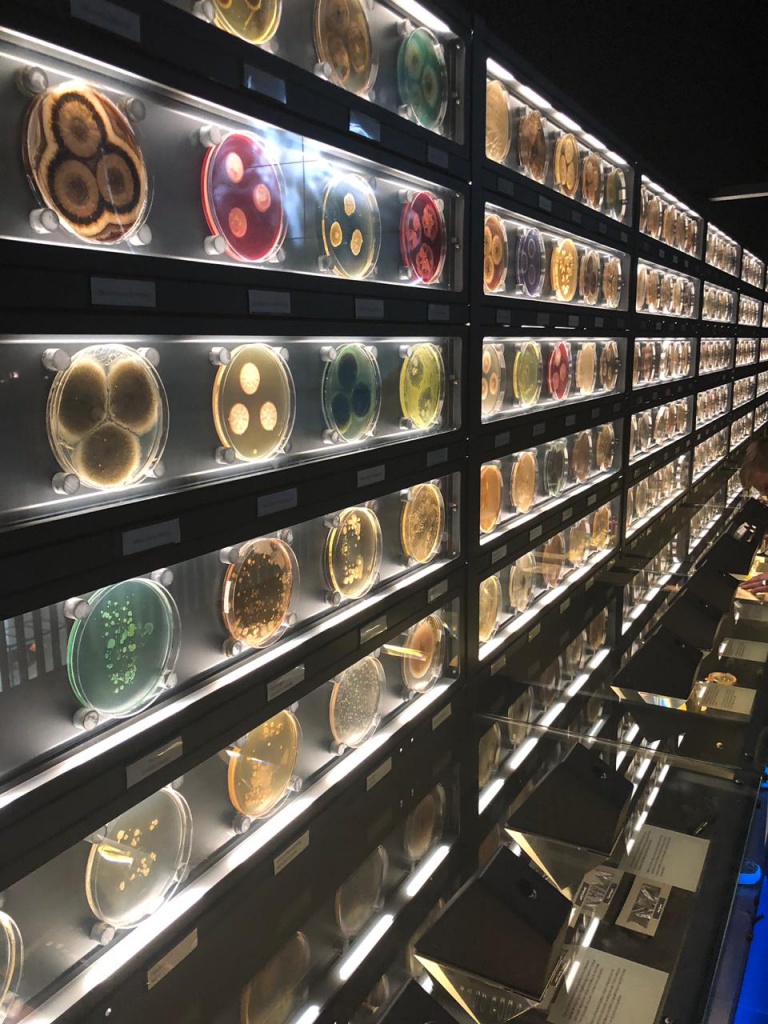
25.jpg

В Амстердаме состоялся Европейский Конгресс по клинической микробиологии и инфекционным заболеваниям (ECCMID)


Конгресс объединил более 12000 участников, включая клиницистов, микробиологов, фармацевтов, педиатров, врачей общей практики и множество других специалистов.
Рабочие сессии Конгресса проводились в виде лекций, интерактивных практикумов, встреч с экспертами рынка, с возможностью задать наиболее актуальные вопросы диагностики, защиты и предотвращения распространения инфекций. Российские специалисты особо выделили секции, посвященные проблеме гетерорезистентности, устойчивости к полимиксину, применения ускоренных методов определения чувствительности. Широко обсуждалась также проблематика инвазивных микозов, пересмотра подходов к антибиотикотерапии, в т.ч. у детей.




Большой интерес был проявлен к секциям, на которых рассматривались подходы к диагностике и определению устойчивости к антимикробным препаратам отдельных микроорганизмов, таких как Candida auris, Klebsiella pneumoniae и др.
Российская делегация была широко представлена среди докладчиков и организаторов секций. Коллективы ведущих научно-исследовательских институтов и медицинских вузов представили интереснейшие материалы по различным темам. Среди них специалисты НИИАХ (Смоленск), НМИЦ гематологии (Москва), НИИ медицинской микологии им. П.Н.Кашкина (Санкт-Петербург), Центральный НИИ Эпидемиологии Роспотребнадзора (г. Москва), НМИЦ АГП им. В.И.Кулакова (Москва), СЗГМУ им. И. И. Мечникова (Санкт-Петербург), СПбГПМУ, Первый МГМУ им. И.М. Сеченова (Москва), СамГМУ (Самара) и многие другие.
Активное участие в работе конгресса традиционно приняли специалисты крупнейших микробиологических лабораторий и научные сотрудники ведущих научно-образовательных организаций РФ. В их числе члены Федерации лабораторной медицины, члены Президиума ФЛМ и профильных структур Федерации - Комитета по микробиологии, Совета по внедрению инновационной и высокотехнологичной микробиологической практики.
Несмотря на насыщенную научную программу, участники конгресса из России в свободное от заседаний время смогли ознакомиться с великолепной архитектурой Амстердама, его живописными каналами, побывать в парке «Кёкенхоф» и полюбоваться цветением тюльпанов, побывать в единственном в мире музее микробов «Микропия», а также в государственном музее, музее Ван Гога, насладиться музыкой Баха в концертном зале «Консертгебау».

Поделитесь этой новостью с коллегами и друзьями










